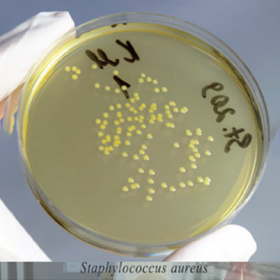
КМАФАнМ
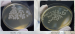
КМАФАнМ

КМАФАнМ
Питательная среда для определения количества мезофильных аэробных и факультативно-анаэробных микроорганизмов сухая (КМАФАнМ)
Для определения общей бактериальной обсемененности пищевых продуктов, фармацевтических и косметических продуктов, воды, объектов окружающей и производственной среды.
Данный продукт предназначен для исследовательских целей.
Срок годности 2 года.
Фасовка 250 г для приготовления 6,0 л среды.
- Стерильность: -
- Форма выпуска: Порошок
- Упаковка: 250 г
- Документы: Для исследовательских целей